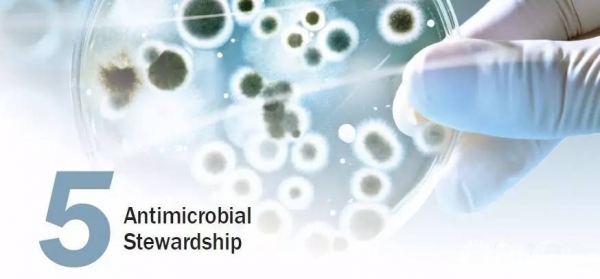

2017年医疗机构关注的10大患者安全问题
2017-03-19 文章来源:患者安全 作者:编译自 ECRI Institute 我要说

电子病历(EHRs)信息安全管理,抗菌药物的管理......2017年医疗机构关注的10大患者安全问题,都有哪些?答案就在本文。
患者安全是每一个医疗机构的首要任务, 为了帮助医疗机构关注患者安全热点问题,2017年3月13日,美国急救研究所(ECRI Institute) 网站发布了《2017年医疗机构关注的10大患者安全问题》年度报告。

1.电子病历(EHRs)信息安全管理

2.加快对未知恶化病变的认识

3.临床决策支持系统的实施与应用

4.检查结果的报告与后续报告结果的综合判断
5.抗菌药物的管理

6.患者身份识别

7.急性医疗照护中阿片类药物的使用与监测

8.非行为健康中心的行为健康问题

9.新的口服抗凝药物的管理

10.医疗机构提升质量安全缺乏系统思维与流程改造

【原文】 https://www.ecri.org/Pages/Top-10-Patient-Safety-Concerns.aspx





 京公网安备11010502051256号
京公网安备11010502051256号